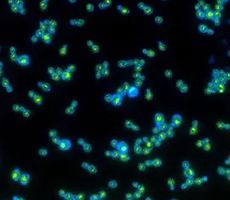
喜歡光的酵母菌——光動(dòng)力酵母菌株

“精密儀器設(shè)備”重點(diǎn)專項(xiàng)項(xiàng)目指南建議的通知
今年6月,廣東省科學(xué)技術(shù)廳發(fā)布關(guān)于征集2024年度廣東省重點(diǎn)領(lǐng)域研發(fā)計(jì)劃“精密儀器設(shè)備”重點(diǎn)專項(xiàng)項(xiàng)目指南建議的通知,旨在重點(diǎn)鼓勵(lì)開展高端科學(xué)測(cè)試分析儀器的研發(fā),為科學(xué)研究和產(chǎn)業(yè)發(fā)展提供先進(jìn)的儀器設(shè)備和工具。